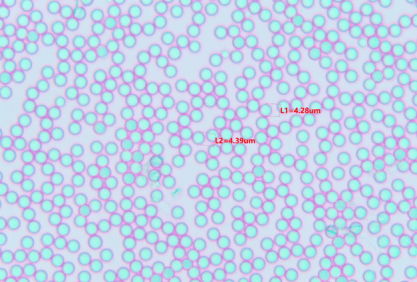
1696991672326803.png

微球制劑產(chǎn)品的質(zhì)量控制
通常評價(jià)微球的指標(biāo)有微球形態(tài)、粒徑及其分布、載藥量、包封率及其釋放度,有時(shí)還包括有關(guān)物質(zhì)和溶劑殘留等項(xiàng)目。
形態(tài)
通過掃描電子顯微鏡或者透射電子顯微鏡觀察微球的形態(tài),如形狀(圓形或類圓形)、表面形貌(光滑或粗糙)、骨架結(jié)構(gòu)(多孔或?qū)嵭?。微球形態(tài)與結(jié)構(gòu)的不同對微球的載藥量以及釋放行為有顯著影響。表面粗糙的微球易吸附藥物結(jié)晶,往往會導(dǎo)致高突釋。通過對微球形態(tài)進(jìn)行觀測,總結(jié)形態(tài)與處方工藝之間的關(guān)系,不但可以對微球的制備機(jī)理進(jìn)行探索,還可以對釋放行為進(jìn)行優(yōu)化。

粒徑及分布
影響微球產(chǎn)品釋放度的關(guān)鍵因素主要是粒徑和粒徑的分布。粒徑測定方法有很多種,主要包括動態(tài)光散射法(DLS)、激光衍射法(LLD)、透射電鏡(TEM)以及掃描電鏡(SEM)、原子力學(xué)顯微鏡(AFM)等。其測量方法各有優(yōu)缺點(diǎn),DLS 法可準(zhǔn)確測量的粒徑范圍較窄,LLD 法測量粒徑范圍為1~1000μm,但其需要的樣品量大,而TEM、SEM易受樣品制備過程影響,AFM 則設(shè)備較復(fù)雜,綜上所述,激光衍射法仍是最常用的測量粒徑及粒徑分布的方法。
載藥量/包封率
載藥量是指微球制劑中所含藥物的質(zhì)量分?jǐn)?shù),而包封率是指微球制劑中包封的藥量占微球制劑中包封與未包封總藥量的比值,二者是衡量制備工藝和成本的重要指標(biāo)。其檢測方法一般是先采用合適的有機(jī)溶劑將微球高分子材料骨架溶解,再根據(jù)藥物的性質(zhì)選擇不同的方法將藥物分離或提取出來,進(jìn)行含量測定。
釋放度
選擇合適的高分子聚合物材料與工藝制備不同結(jié)構(gòu)的載藥微球,使活性成分按照預(yù)期的藥代動力學(xué)模型釋放。對于可生物降解材料,溶脹和溶蝕機(jī)制也是控制藥物釋放的主要因素。釋放介質(zhì)的組成、pH 值、離子強(qiáng)度、滲透壓和溫度等都會對釋放速率產(chǎn)生影響。在載藥微球的研發(fā)階段,應(yīng)確定好合適的體外釋放條件,并根據(jù)體內(nèi)釋放條件建立體內(nèi)、體外相關(guān)性。
高分子聚合物的玻璃化轉(zhuǎn)變溫度與晶型改變。
在高分子聚合物材料析出形成微球后,聚合物的玻璃化轉(zhuǎn)變溫度(Tg )會發(fā)生改變。當(dāng)聚合物和藥物或溶劑共同存在時(shí),易產(chǎn)生共價(jià)鍵吸引力,使得聚合物的 Tg降低。比較常用的 Tg 檢測方法是差示熱分析法和差示掃描量熱法。高分子聚合物的晶型與結(jié)晶度的變化可以從側(cè)面反映藥物的釋放速率和微球的降解速度。
有機(jī)溶劑殘留
制備過程中引入的油相(有機(jī)溶劑)在固化的過程中會存在未能完全除去的問題,諸如丙酮、乙酸乙酯、二氯甲烷等的殘留不僅影響微球儲存的穩(wěn)定性,還會在注射后引起人體的副作用,因此每個(gè)國家的藥典都對微球的有機(jī)溶劑殘留量有著嚴(yán)格的要求。不同的有機(jī)溶劑毒性不同,限度也有所不同,目前常規(guī)使用氣相色譜法進(jìn)行殘留有機(jī)溶劑的檢測。
另外,通過材料降解實(shí)驗(yàn)考察分子量,緩釋微球的微生物檢查等也是微球藥物質(zhì)量評價(jià)的指標(biāo)。
免責(zé)聲明:文章來源網(wǎng)絡(luò) 以傳播知識、有益學(xué)習(xí)和研究為宗旨。 轉(zhuǎn)載僅供參考學(xué)習(xí)及傳遞有用信息,版權(quán)歸原作者所有,如侵犯權(quán)益,請聯(lián)系刪除。
標(biāo)簽: 微球制備
- 上一條沒有了
- 下一條常見的幾種緩釋微球的制備方法

